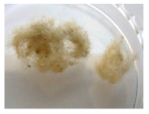
Sustainability 11 06440 i001 Sustainability 11 06440 i001

Comparison of Methods for Pretreatment and Quantification of Bulk Asbestos Samples for Polarized Light Microscopy Analysis to Evaluate Asbestos-Containing Waste
Abstract
1. Introduction
2. Materials and Methods
2.1. Sample Selection
2.2. Analyst Selection
2.3. Comparison of Sample Pretreatment for Qualitative Analysis and Quantification of Asbestos
2.4. Comparison of the Quantitative Analysis by VE and PC
2.5. Statistical Analysis
3. Results
3.1. Comparison of Sample Pretreatment Methods by Qualitative Analysis and Quantification (VE) of Asbestos
3.2. Quantitative Analysis (VE) Result by Experience of Analysts
3.3. Comparison of the Quantitative Analysis by VE and PC
4. Discussion
5. Conclusions
Supplementary Materials
Author Contributions
Acknowledgments
Conflicts of Interest
References
- ATSDR. Toxicological Profile for Asbestos. US Department of Health and Human Services, Public Health Service, Agency for Toxic Substances and Disease Registry. Available online: https://www.atsdr.cdc.gov/toxprofiles/tp61.pdf (accessed on 2 September 2019).
- Wilk, E.; Krówczyńska, M.; Zagajewski, B. Modelling the Spatial Distribution of Asbestos—Cement Products in Poland with the Use of the Random Forest Algorithm. Sustainability 2019, 11, 4355. [Google Scholar] [CrossRef]
- IARC. IARC Monographs: Vol. 100C Asbestos, International Agency for Research on Cancer. 2012. Available online: http://monographs.iarc.fr/ENG/Monographs/vol100C/mono100C-11.pdf (accessed on 2 September 2019).
- Jo, H.; Jang, Y.N.; Jo, J.H. A low temperature detoxification method for treatment of chrysotile-containing waste roofing slate. Minerals 2017, 7, 144. [Google Scholar] [CrossRef]
- Ham, S.; Hwang, S.; Yoon, C.; Park, D. Review on asbestos analysis. J. Korean Soc. Occup. Environ. Hyg. 2009, 19, 213–232. [Google Scholar]
- Hwang, S.; Park, W. Application of asbestos management index and asbestos recognition in public buildings in South Korea. Hum. Ecol. Risk Assess. 2016, 22, 1542–1551. [Google Scholar] [CrossRef]
- Yi, G.; Yoon, C.; Han, J.; Yoon, M.; Jung, S.; Lee, J.; Lee, I.; Park, D. Development of asbestos quality control samples for proficiency analytical testing–evaluation of amosite and chrysotile quality control samples. J. Korean Soc. Occup. Environ. Hyg. 2009, 19, 288–296. [Google Scholar]
- U.K.HSE. Asbestos: The Survey Guide 2nd Ed., HSG264. 2012. Available online: http://www.hse.gov.uk/pUbns/priced/hsg264.pdf (accessed on 2 September 2019).
- U.S.EPA. Method for the Determination of Asbestos in Bulk Building Materials, EPA/600/R-93/116. 1993. Available online: http://nepis.epa.gov/Exe/ZyPURL.cgi?Dockey=9100TKSO.TXT (accessed on 2 September 2019).
- OSHA. Polarized Light Microscopy of Asbestos, ID-191, Occupational Safety and Health Administration. 1992. Available online: https://www.osha.gov/dts/sltc/methods/inorganic/id191/id191.pdf (accessed on 2 September 2019).
- NIOSH. ASBESTOS (bulk) by PLM, NMAM 9002 (Issue 2), National Institute for Occupational Safety and Health. 1994. Available online: https://www.cdc.gov/niosh/docs/2003-154/pdfs/9002.pdf (accessed on 2 September 2019).
- KOSHA. Guidelines for Workplace Measurement Analysis: Asbestos; KOSHA CODE A-1-022; Korea Occupational Safety and Health Agency: Ulsan, Korea, 2006. [Google Scholar]
- MOE. Guidelines for Asbestos Management in Buildings; Ministry of Environment: Sejong-si, Korea, 2009.
- U.S.EPA. Interim Method for the Determination of Asbestos in Bulk Insulation Samples, EPA-600/M4-82-020. 1982. Available online: http://nepis.epa.gov/Exe/ZyPURL.cgi?Dockey=20009K0U.TXT (accessed on 2 September 2019).
- U.S.EPA. Asbestos Content in Bulk Insulation Samples: Visual Estimates and Weight Composition. 1988. Available online: http://nepis.epa.gov/Exe/ZyPURL.cgi?Dockey=20012KKM.TXT (accessed on 2 September 2019).
- CARB. Determination of Asbestos: Content of Serpentine Aggregate, Method 435, California Air Resources Board. 1991. Available online: https://www.arb.ca.gov/testmeth/vol3/m_435.pdf (accessed on 2 September 2019).
- Webber, J.; Janulis, R.; Carhart, L.; Gillespie, M. Quantitating asbestos content in friable bulk samples: Development of a stratified point-counting method. Am. Ind. Hyg. Assoc. J. 1990, 51, 447–452. [Google Scholar] [CrossRef]
- Santee, K.; Lott, P. Asbestos analysis: A review. App. Spec. Rev. 2003, 38, 355–394. [Google Scholar] [CrossRef]
- KOSHA. Bulk Asbestos Analysis Method Using Polarized Light Microscope; Korea Occupational Safety and Health Agency: Ulsan, Korea, 2009. [Google Scholar]
- U.K.HSE. Asbestos: The Analysts’ Guide for Sampling, Analysis and Clearance Procedures, HSG248. 2006. Available online: http://www.hse.gov.uk/pUbns/priced/hsg248.pdf (accessed on 2 September 2019).
- McCrone, W. Asbestos Identification; McCrone Research Institute: Chicago, IL, USA, 1988. [Google Scholar]
- Thompson, M.; Wood, R. The international harmonised protocol for the proficiency testing of (chemical) analytical laboratories. Pure Appl. Chem. 1993, 65, 2123–2144. [Google Scholar] [CrossRef]
- Harvey, B.; Perkins, R.; Nickerson, J.; Newland, A.; Beard, M. Formulating bulk asbestos standards. Asbestos Issues 1991, 4, 22–29. [Google Scholar]
- U.S.EPA. Procedure for Measuring Low Levels of Asbestos in Bulk Materials. In Development and Evaluation of Polarized Light Microscopy (PLM); U.S.EPA: Washington, DC, USA, 1989. [Google Scholar]
- Perkins, R. Point-counting technique for friable asbestos-containing materials. Microscope 1990, 38, 29–39. [Google Scholar]
- NIST. Bulk Asbestos Analysis, NIST Handbook 150-3, National Voluntary Laboratory Accreditation Program. 2006. Available online: https://www.nist.gov/document-16550 (accessed on 8 November 2019).
- New York State. Polarized-Light Microscope Methods for Identifying and Quantitating Asbestos in Bulk Samples, New York State Department of Health, 198.1. 2005. Available online: https://www.wadsworth.org/sites/default/files/WebDoc/I198_1_09_0.pdf (accessed on 2 September 2019).
- Chrysotile Institute. Monographs and Reports, Report of an IPCS Working Group Meeting on the Reduction of Asbestos in the Environment—Internal Technical Report. 1988. Available online: http://www.chrysotileassociation.com/fr/sc_publi/ipcs_report.php (accessed on 2 September 2019).
- Militello, G.M.; Sanguineti, E.; Yus González, A.; Mantovani, F.; Gaggero, L. The Concentration of Asbestos Fibers in Bulk Samples and Its Variation with Grain Size. Minerals 2019, 9, 539. [Google Scholar] [CrossRef]
- U.K.HSE. Asbestos: The analysts’ guide for sampling, analysis and clearance procedures, HSG248. 2005. Available online: http://www.hse.gov.uk/pUbns/priced/hsg248.pdf (accessed on 8 November 2019).





| Origin of Samples | N | Sample ID | Asbestos Content (%) | Image of Sample |
|---|---|---|---|---|
| 5715 | Not containing asbestos (0) | ![]() | ||
| 6953 | CHRY (5) | ![]() | ||
| 7831 | CHRY (6) | ![]() | ||
| 9616 | CHRY (4) | ![]() | ||
| 6624 | AMOS (4) CHRY (1) | ![]() | ||
| BAPAT | 10 | 9583 | CROC (2) | ![]() |
| 9622 | CHRY (4) | ![]() | ||
| 3428 | CHRY (3) | ![]() | ||
| 8615 | CHRY (6) | ![]() | ||
| 8993 | ANTH (3) | ![]() | ||
| 091 | CHRY (20) AMOS (1) | ![]() | ||
| KOSHA-PAT | 3 | 092 | CHRY (11) | ![]() |
| 094 | CHRY (50) | ![]() | ||
| 1000 (Roof slate) | CHRY (8) | ![]() | ||
| Field sample | 3 | 2000 (Ceiling textile) | CHRY (8) | ![]() |
| 3000 (Floor tile) | CHRY (3) | ![]() | ||
| Total | 16 |
| Category | Crushing and Mixing | Ashing | Acid Washing | Ashing and Acid Washing | |
|---|---|---|---|---|---|
| A | 5 (33.3) | 13 (86.6) | 12 (80.0) | 15 (100.0) | |
| No. of samples with asbestos identified by analysts among 15 asbestos-containing samples (%) | B | 5 (33.3) | 13 (86.6) | 12 (80.0) | 15 (100.0) |
| C | 3 (20.0) | 11 (73.3) | 10 (66.7) | 13 (86.6) | |
| Sample pretreatment time consumed (min) | Act. 1 | Crushing 5 | Weighing 5 | Weighing 5 | Weighing 5 |
| Act. 2 | Slide 5 | Heating 360 | Acid 10 | Heating 360 | |
| Act. 3 | - | Slide 5 | Drying 120 | Acid 30 | |
| Act. 4 | - | - | Slide 5 | Drying 120 | |
| Act. 5 | - | - | - | Slide 5 | |
| Total time consumed (min) | 10 | 370 | 140 | 520 |
| Sample ID | Status | Crushing and Mixing | Ashing | Acid Washing | Ashing and Acid Washing |
|---|---|---|---|---|---|
| 1000 | Chrysotile content | 5.0 | 7.0 | 20.0 | 60.0 |
| Residue | 100.0 | 87.9 | 95.0 | 50.9 | |
| Chrysotile concentration | 5.0 | 6.2 | 19.0 | 30.5 | |
| Reference concentration | 8.0 | ||||
| 2000 | Chrysotile content | 7.0 | 10.0 | 10.0 | 30.0 |
| Residue | 100.0 | 82.7 | 83.3 | 26.7 | |
| Chrysotile concentration | 7.0 | 8.3 | 8.3 | 8.0 | |
| Reference concentration | 7.3 | ||||
| 3000 | Chrysotile content | N.D. | 2.0 | 2.0 | 5.0 |
| Residue | 100.0 | 75.1 | 99.2 | 67.2 | |
| Chrysotile concentration | N.D. | 1.5 | 2.0 | 3.4 | |
| Reference concentration | 2.5 | ||||
| Sample ID | Types of Error | True Asbestos Type | Analyst | ||
|---|---|---|---|---|---|
| A | B | C | |||
| 9583 1 | Misclassification | CROC | AMOS | AMOS | AMOS |
| AMOS | CROC | CROC | CROC | ||
| 8893 1 | False negative | ANTH | ANTH | ANTH | N.D. |
| 091 2 | AMOS | AMOS | AMOS | N.D. | |
| Subject | Mean ± SD | Repeated Measurement ANOVA | |
|---|---|---|---|
| p-value | |||
| A vs. B | 0.95 ± 0.63 | 0.91 ± 1.16 | 0.889 |
| A vs. C | 0.95 ± 0.63 | 1.85 ± 1.51 | 0.021 |
| B vs. C | 0.91 ± 1.16 | 1.85 ± 1.51 | 0.037 |
| Level of Concentrations | Concentration/Reference (Mean ± SD) | ||
|---|---|---|---|
| Analyst A | Analyst B | Analyst C | |
| Less than 10% | 0.93 ± 0.81 | 1.11 ± 1.49 | 2.15 ± 1.85 |
| 10% or higher | 1.11 ± 0.38 | 0.77 ± 0.62 | 1.73 ± 1.00 |
| Analyst | Estimated Method | Concentration/Reference | Mean ± SD | |||
|---|---|---|---|---|---|---|
| 1 | 2 | 3 | 4 | |||
| A | VE | 1.14 | 0.60 | 0.80 | 0.60 | 0.79 ± 0.26 |
| PC | 0.84 | 0.80 | 1.14 | 0.54 | 0.83 ± 0.25 | |
| B | VE | 0.29 | 4.67 | 0.40 | 0.56 | 1.48 ± 2.13 |
| PC | 0.36 | 3.50 | 1.10 | 0.80 | 1.44 ± 1.41 | |
| C | VE | 2.23 | 6.67 | 0.60 | 1.88 | 2.84 ± 2.65 |
| PC | 0.78 | 2.36 | 1.81 | 0.54 | 1.37 ± 0.86 | |
© 2019 by the authors. Licensee MDPI, Basel, Switzerland. This article is an open access article distributed under the terms and conditions of the Creative Commons Attribution (CC BY) license (http://creativecommons.org/licenses/by/4.0/).
Share and Cite
Ham, S.; Hwang, S.; Yoon, C. Comparison of Methods for Pretreatment and Quantification of Bulk Asbestos Samples for Polarized Light Microscopy Analysis to Evaluate Asbestos-Containing Waste. Sustainability 2019, 11, 6440. https://doi.org/10.3390/su11226440
Ham S, Hwang S, Yoon C. Comparison of Methods for Pretreatment and Quantification of Bulk Asbestos Samples for Polarized Light Microscopy Analysis to Evaluate Asbestos-Containing Waste. Sustainability. 2019; 11(22):6440. https://doi.org/10.3390/su11226440
Chicago/Turabian StyleHam, Seunghon, Sungho Hwang, and Chungsik Yoon. 2019. "Comparison of Methods for Pretreatment and Quantification of Bulk Asbestos Samples for Polarized Light Microscopy Analysis to Evaluate Asbestos-Containing Waste" Sustainability 11, no. 22: 6440. https://doi.org/10.3390/su11226440
APA StyleHam, S., Hwang, S., & Yoon, C. (2019). Comparison of Methods for Pretreatment and Quantification of Bulk Asbestos Samples for Polarized Light Microscopy Analysis to Evaluate Asbestos-Containing Waste. Sustainability, 11(22), 6440. https://doi.org/10.3390/su11226440